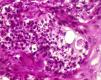
fig0010

La paracoccidioidomicosis (PCM) es una micosis sistémica causada por un hongo dimórfico.
El hongo Paracoccidioides brasiliensis (P. brasiliensis), que habita en suelos y en plantas de áreas tropicales y subtropicales. Endémica de América del Sur es la más frecuente de las micosis profundas en Paraguay.
La infección se produce en las primeras décadas de la vida por inhalación de esporas, llegando a los pulmones. Puede diseminarse por vía sanguínea o linfática a otras partes del cuerpo afectando piel, mucosas, glándulas suprarrenales y otros órganos1–4.
Las 2 principales presentaciones clínicas de la PCM son la forma crónica y la forma aguda/subaguda. La primera abarca hasta el 90% de los casos, y afecta característicamente a agricultores de sexo masculino, entre 30 y 60 años de edad. La mayor afectación masculina se ha asociado a la presencia de receptores 17-β-estradiol en el citoplasma de P. brasiliensis que, al interactuar con la hormona femenina, inhiben la transformación de la forma micelial a la de levadura del hongo, indispensable para la infección3–7.
La forma aguda/subaguda (tipo juvenil) constituye menos del 10% de los casos, afectando principalmente a jóvenes con una inmunidad mediada por células deprimidas. De evolución rápida (4 a 12 semanas), con alteración del sistema monocito-macrófago y lesiones polimorfas en piel (nodulares, forunculoides, verrugosas, úlcero-granulomatosas, moluscoides)5,7–9.
El gold standard para el diagnóstico es el cultivo, el cual debe realizarse bajo estrictas normas de bioseguridad. Crece en forma micelial a temperatura ambiente, y como levadura in vitro y en tejidos a 37°C1–5. Otros métodos de diagnóstico comprenden estudios serológicos como la inmunodifusión y moleculares como la PCR1,2,10. La histopatología permite la visualización de estructuras fúngicas, encontrándose granulomas bien o escasamente organizados, de acuerdo a la respuesta inmunitaria1,7.
Las enfermedades infecciosas frecuentemente asociadas son la tuberculosis (5-10%), las parasitosis intestinales, la enfermedad de Chagas, la sífilis, otras micosis superficiales y profundas y el sida. Entre las no infecciosas destacan el linfoma no-Hodgkin y algunos carcinomas.
La asociación con el tabaquismo se describe en un alto porcentaje de los pacientes1,5,8.
Los pacientes con formas graves de PCM, con pérdida de peso de más del 10%, con dificultad respiratoria o síntomas neurológicos deben ser ingresados.
El tratamiento de elección es itraconazol de 200-400mg/día vía oral 6 a 12 meses, con tasas de curación que oscilan entre el 88 al 100% y un índice de recidiva del 3%. En las formas graves anfotericina B, de 0,8-1mg/kg/día en goteo intravenoso hasta lograr una mejoría clínica que permita continuar por vía oral1–3,7. Otras alternativas incluyen trimetoprim-sulfametoxazol, voriconazol y fluconazol. Para considerar una respuesta favorable al tratamiento se deben realizar evaluaciones periódicas que incluyan criterios clínicos, micológicos, radiológicos e inmunológicos. El retraso terapéutico aumenta la mortalidad hasta un 30%, y permite la aparición de secuelas potencialmente incapacitantes como fibrosis a nivel del aparato respiratorio1–3,5,7.
Presentamos una mujer de 21 años, ama de casa, indígena, procedente de medio rural húmedo y boscoso de Paraguay, con lesiones cutáneas de 2 meses de evolución en espalda, rostro, cuello, abdomen y extremidades. La paciente refería sensación febril de predominio vespertino, ictericia, disnea, astenia, anorexia y pérdida de peso no cuantificada. Negaba enfermedades de base, tabaquismo, consumo de alcohol y uso de drogas ilícitas.
En el examen físico se apreciaban pápulas y placas eritematovioláceas, algunas con depresión central y costra hemática, de predominio facial (fig. 1). Además, se objetivaba ictericia, ascitis y adenopatías submandibulares y cervicales de 1,5 a 3cm de diámetro. Murmullo vesicular abolido en ambas bases pulmonares y fiebre de 38,5°C, signos vitales estables.
En el análisis de sangre destacaba: hemoglobina 7,4g/dl; hematocrito 21% y leucocitos: 11.800cel/mm3 (neutrófilos: 82%, linfocitos: 10%, monocitos: 6% y eosinófilos: 2%); plaquetas: 124.000cel/mm3; GOT 127U/l (VN: 32); GPT75 U/l (VN: 33); fosfatasa alcalina: 4.694UI/l (VN: 300); bilirrubina total: 10,1mg/dl; bilirrubina directa: 4,8mg/dl; bilirrubina indirecta: 6,1mg/dl; albúmina: 1,3g/dl (>3,5g/dl); TP/TTPA: 50%/45s. Las serologías de VIH, sífilis, VHC, HBsAg y VHA resultaron negativas. Los cultivos de esputo y líquido gástrico fueron negativos para BAAR y hongos.
La ecografía abdominal mostró hepatomegalia y líquido libre en cavidad abdominal en gran cantidad y derrame pleural bilateral. La TAC de abdomen no evidenció afectación de las glándulas suprarrenales.
El estudio anatomopatológico confirmó la existencia de hiperplasia seudoepiteliomatosa y granulomatosis supurativa pandérmica, con células gigantes multinucleadas y esporos micóticos de pared birrefringente y exoesporulación (fig. 2).
En el frotis ganglionar se observaron células gigantes multinucleadas con esporos micóticos compatibles con P. brasiliensis. Con todo ello se estableció el diagnóstico final de PCM aguda diseminada.
Se pautó tratamiento con 3g de anfotericina B a 50mg/día, con suspensión de la administración algunos días por alteraciones transitorias de la función renal, con mejoría de las lesiones cutáneas (fig. 3), la función hepática (FA: 1.256UI/l al mes del tratamiento) y del estado general. Para completar la terapia se indicó itraconazol 200mg/día al alta durante 6 meses. En la actualidad, lleva 2 meses en tratamiento y 2,5g de anfotericina acumulados no habiendo presentado recidivas.
La PCM se caracteriza por el gran polimorfismo de las lesiones cutáneas que se presentan como pápulas, nódulos, placas eritematodescamativas, verrugosas, úlceras con fondo granulomatoso con punteado hemorrágico, siendo las lesiones moluscoides (cara, alrededor de nariz y boca, las localizaciones más frecuentes en esta paciente) de presentación excepcional1.
Este tipo de lesiones moluscoides nos obligan a descartar criptococosis, histoplasmosis, micobacteriosis atípicas, molusco contagioso, leishmaniasis diseminada y la enfermedad de Hansen1,2,5,7.
Destacamos del presente caso que se trata de una mujer joven, en edad fértil procedente de un área endémica con condiciones propicias para el hábitat del hongo, sin inmunosupresión excepto un estado de malnutrición, con lesiones moluscoides de predominio facial que obligaron a descartar múltiples diagnósticos diferenciales y otras comorbilidades. Los fenómenos migratorios hacen necesario el conocer estas enfermedades infecciosas, ya que pueden presentarse en otros continentes10.